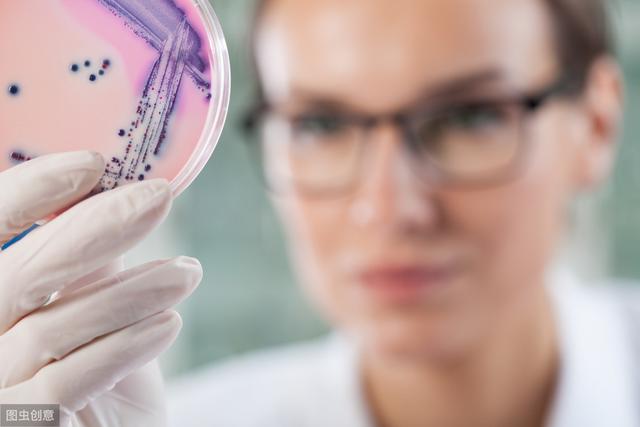

原标题:女人的难“炎”之隐__阴道炎的防治
阴道炎是女人常见的疾病之一,各年龄组均可发病。正常的阴道内有许多种微生物存在,它们相互抗衡,使阴道微生物的数量处在动态平衡,然后维护阴道环境。一般的情况下阴道为酸性环境,具有必定的自我防护能力。阴道乳杆菌、阴道的酸碱性、雌激素是坚持阴道平衡的首要的要素,当这三个首要的要素其间任何一个发作问题,都会使病原体易于侵略,导致阴道炎的发作。
一、阴道炎的常见分类、病因及医治如下:
二、阴道炎的医治准则
1、及时就诊,有清晰的目的性的正规查看和医治,遵医嘱足量、足阶段进行及时有用的医治。勿盲目自行用药,不行自行停药。
2、 正确运用阴道制剂。
3、医治期间防止无维护性交。
4、医治期间应调整日子方式,合理饮食(削减高糖食物的摄入)、恰当运动、规则日子,一起防止劳累,减轻压力。
5、如阴道炎重复发作,应及时就诊,再次查看和医治。
三、用药需求留意的几点
1、如您运用甲硝唑或替硝唑:用药期间和用药前后应防止喝酒和含酒精饮料,防止食用含酒精食物,防止运用含酒精的药品。
2、阴道栓剂的运用方法
①洗净双手,清洁外阴。除掉栓剂外封物。如栓剂太软,则应将其带着外包装放在冰箱的冷冻室或冰水中冷却顷刻,使其变硬,然后除掉外封物。用清水或水溶性润滑剂涂在栓剂的顶级部。
②患者平卧于床上,双膝屈起并分隔,戴好手套或指套,将栓剂顶级部向阴道口塞入,并用于以向下、向前的方向悄悄推人阴道深处(大约一指的间隔)。置入栓剂后患者应合拢双腿,坚持仰卧姿态或臀部举高,以使药物在阴道内停留时间更长。
③在给药后1-2小时内尽量不排尿,防止影响药效。
④一般于睡前给药,以便药物充沛吸收,并可防止药栓遇热溶解后外流。如需每日2次给药,迟早各运用1次。如有液体流出,可运用护垫,防止弄脏衣裤。
⑤一般月经期应停药,顺延到出血中止后运用。
⑥用药期间防止性日子。
⑦一般情况下用药前清洗外阴即可,假如分泌物许多,可在用药前冲刷阴道,但牢记不要清洗过度,防止损坏阴道内环境。
⑧栓剂分为阴道栓和肛门栓,留意区别,防止用错药。
四、阴道炎的防备准则
因机体的抵抗力下降,阴道内环境发作变化,机体天然防护功用遭到损坏而发作阴道感染,故需做好以下防备措施:
1、 养成杰出的个人日子、卫生习惯。不过度清洁阴道,不必各种洗液清洁阴道及外阴,每天用清水清洗外阴即可;每天替换内裤(尽可能穿全棉的内裤),及时清洗,阳光下晾干;尽可能的防止穿紧身衣裤,平常最好穿棉质内裤。
2、月经期间,勤换卫生巾、卫生棉条等;平常削减护垫的运用。
3、 合理饮食(削减高糖食物的摄入)、恰当运动、规则日子,防止劳累,减轻压力,以进步身体免疫力。
4、如患有糖尿病,需将血糖控控制在正常范围内。
5、防止频频性日子及替换性伴侣,性日子前后留意卫生,做好维护措施。
(药剂科 栗芳 图片来源于网络)
-
责任编辑:

 共筑社会“安全感”|沃尔沃汽车鼎力支持上海市“医苑新星”结业仪式
共筑社会“安全感”|沃尔沃汽车鼎力支持上海市“医苑新星”结业仪式 重庆丰益中医肛肠医院看病贵不贵?收费透明,看病不贵
重庆丰益中医肛肠医院看病贵不贵?收费透明,看病不贵 校园直击!紫竹蜂胶口腔膜治愈风潮燃动福州!
校园直击!紫竹蜂胶口腔膜治愈风潮燃动福州! 万众瞩目:络病大会召开 微血管病变防治开辟新局面
万众瞩目:络病大会召开 微血管病变防治开辟新局面 毓婷x学院奖云课堂完美收官|“毓”青春同行,创意步履不“婷”
毓婷x学院奖云课堂完美收官|“毓”青春同行,创意步履不“婷” 发现就是中晚期的结直肠癌,其实有办法可以避免!
发现就是中晚期的结直肠癌,其实有办法可以避免! “毓”见别YOUNG青春——毓婷携手学院奖2022再启新程
“毓”见别YOUNG青春——毓婷携手学院奖2022再启新程 成都中德肾病医院付冬梅--专业经验技术 让你放心无忧
成都中德肾病医院付冬梅--专业经验技术 让你放心无忧